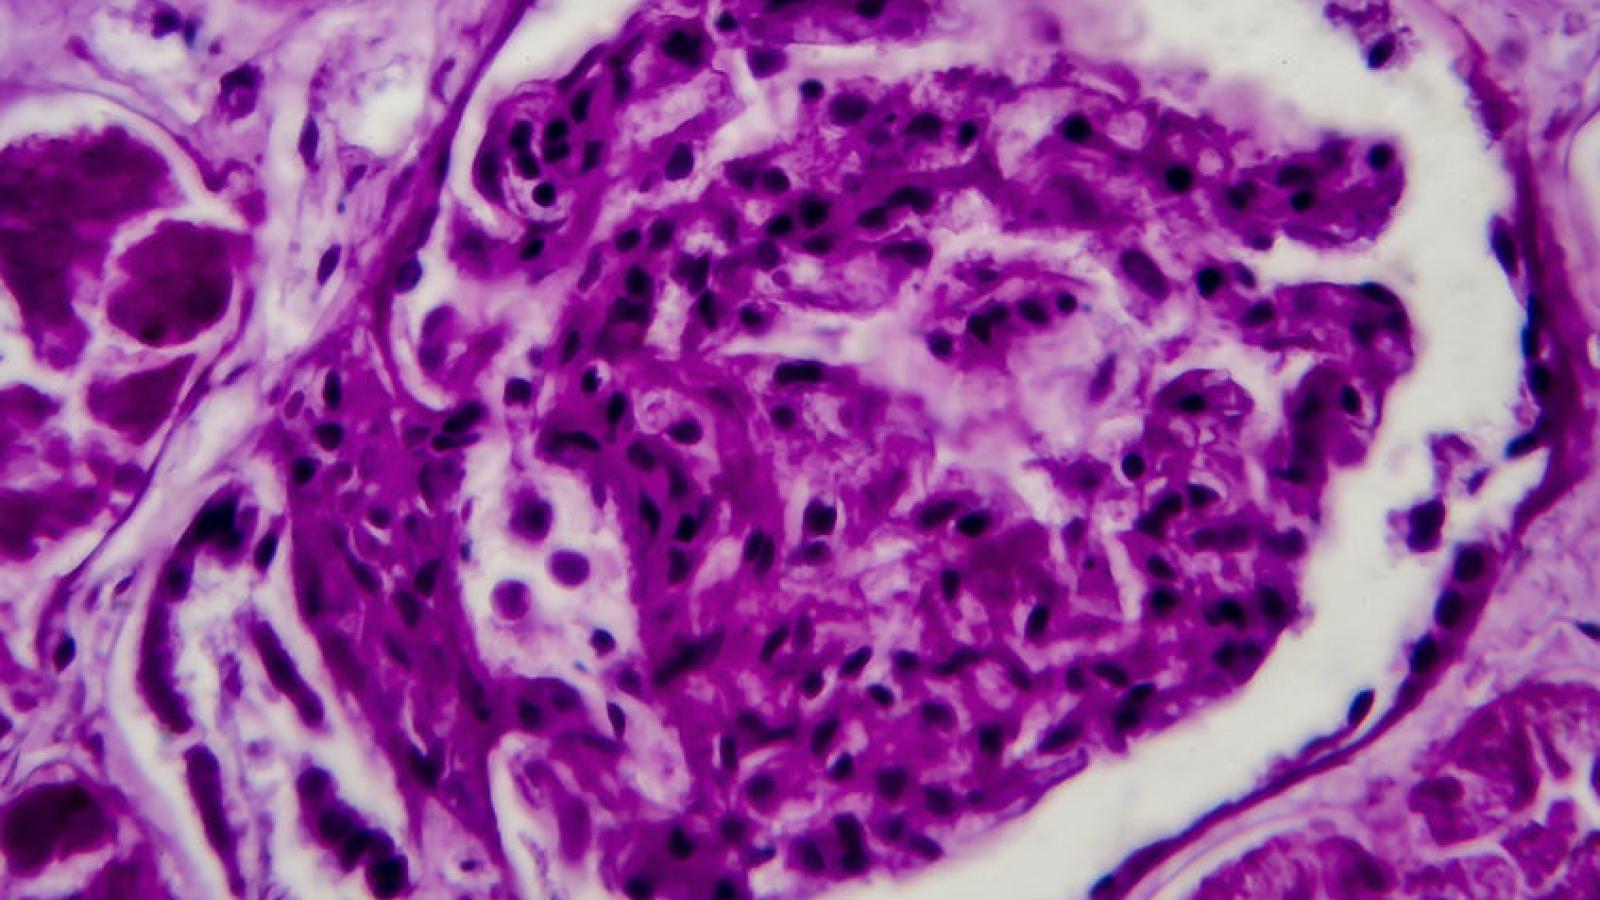
DPGN, lupus, nephritis, GN, glomerulonephritis, biopsy, kidney

Lupus

Dr. John Cush RheumNow
3 years 3 months ago
Anti-CD19 CAR T cell therapy for refractory #SLE published in Nature Medicine. 5 pts (22yrs) w/ refractory dz, active SLE (SLEDAI=16). Autologous pt T cells transduced to CD19 CAR Tcells, and lead to remission in 5/5 w/in 3 mos & maintained median 8 mos https://t.co/0epnffCNEN https://t.co/IMRzhOzgei

The big news this week: the approval of deucravacitinib (a new class of drug?) for psoriasis; the 2022 ACR guidance on glucocorticoid-induced osteoporosis; a national poll of older adults over the age of 50 who claimed self-reported or doctor-diagnosed arthritis; and much more. Let's review these and other news, journal reports and announcements from this past week.

Dr. John Cush RheumNow
3 years 3 months ago
Lupus (LUMEN) registry of 440 SLE compared to non-SLE pts, shows lupus pts have less screening for cervical cancer (HR 0.75), but SLE has more screening for HTN (HR 1.35), DM (HR 2.46), hyperlipidemia (HR 3.19) & Influenza & pneumovax vaccines https://t.co/e5ZGJswVds https://t.co/WQmhM0OZgl


Donald Thomas, MD lupuscyclopedia
3 years 3 months ago
I just posted "Free Lupus Encyclopedia Book give away ... register to win... even international addresses are welcome" on Reddit
https://t.co/Pa4h75vcW1

Dr. John Cush RheumNow
3 years 3 months ago
The 2022 ACR abstracts are published and posted for you. Let the Learning begin! https://t.co/ZqMAc8jV3U https://t.co/3iCGnzsPI5


Catherine Sims, MD DrCassySims
3 years 3 months ago
A summary slide from #grandrounds this morning on a talk about trying to differentiate #lupus #nephritis from #preeclampsia #RheumTwitter #MedTwitter https://t.co/R2rhhgQYIm


Dr. John Cush RheumNow
3 years 3 months ago
Immunosuppresive (IST; MMF or AZA) withdrawl in 96 stable Lupus Nephritis pts also on HCQ. After 2 years, Relapse occurred in 12.5% w/ IST continued & 27.3% with IST D/C (Not noninferior). Less Severe SLE flares (renal & extrarenal) w/ IST continuation https://t.co/XWmJpkqhG9 https://t.co/gYM24QIiYz

A retrospective study of dermatomyositis (DM) patients with COVID-19, shows that DM patients without comorbidities fair well (with regard to mortality and hospitalisation).
Can we predict the bad outcomes? Like when ITP evolves into SLE; or when psoriasis will develop arthritis; or if Sjogren's will develop lymphoma? Let's dive in and review these journal reports and this past week's news from RheumNow.com.
A phase 2 trial using litifilimab, a humanized monoclonal antibody binding to blood dendritic cell antigen 2 (BDCA2), demonstrated clinical efficacy in adults with systemic lupus erythematosus (SLE).
By targeting BDCA2 on plasmacytoid dendritic cells, researchers were able to suppresses type I interferon, thought to be instrumental in the pathogenesis of SLE.

Dr. John Cush RheumNow
3 years 3 months ago
Rheums! Have a Rheumatology question or case for Jack Cush? Record it here and we may feature it on an upcoming podcast. Tell us your name and where you practice rheumatology.
https://t.co/1aSrRsLkel https://t.co/gmh155ty6w


Dr. John Cush RheumNow
3 years 3 months ago
Study of 130 patients with ITP (w/ 10 later Dx SLE (30 mos F/U). Risk factors for ITP developing SLE included young age (< 40yrs; OR 6.3), organ bleeding (OR 13.7), and ANA (≥ 1:160; OR 6.6) https://t.co/XSJdio2rR1 https://t.co/oCyFjJnxTX


Dr. John Cush RheumNow
3 years 3 months ago
Voclosporin Efficacy and Safety in Lupus Nephritis
An integrated analysis of two pivotal trials of voclosporin, a calcineurin inhibitor, in lupus nephritis patients saw significant improvement in complete renal responses (CRR) at one year.
https://t.co/LSjmRB2Zr3 https://t.co/z9MoJ0uRzz

An integrated analysis of two pivotal trials of voclosporin, a calcineurin inhibitor, in lupus nephritis patients saw significant improvement in complete renal responses (CRR) at one year.

Dr. John Cush RheumNow
3 years 3 months ago
ANA Increasing? Part of the NHANES survey, ANA (IIF on HEp-2 cells) was performed on 13,519 in 3 periods: 1988-1991, 1999-2004, and 2011-2012. ANA+ was
11% 1988-1991
11.4% 1999-2004
16.1% 2011-2012 (P <0.0001)
Meaning ~22.3, ~26.6, &~41.5 mil had +ANAs https://t.co/vWYJci3uDV https://t.co/SEIbrYRoRJ

Poster Hall
Poster Hall